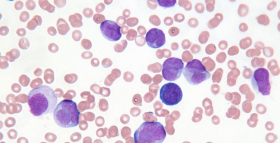

Виберіть своє місто
Для перегляду доступних досліджень та термінів їх виконання

Увійти
Замовити дослідження через кабінет
Замовити дослідження
Служба підтримки
На звʼязку щодня з 07:00 до 20:00
Питання та відповіді
Стати партнером Діла
Відправити pdf на пошту
Заявка на співпрацю
Отримати результати
Новини
 всі статті
всі статті
 новини
новини
 вагітність
вагітність
 здорова дитина
здорова дитина
 сексуальне здоров'я
сексуальне здоров'я
 здоровий спосіб життя
здоровий спосіб життя
 менопауза
менопауза
25.10.2017
13 жовтня у Києві з великим успіхом відбулася спеціалізована ендокринологічна колегія на тему «У фокусі – порушення кісткового метаболізму. Практичні алгоритми», організована експертами медичної лабораторії ДІЛА для практикуючих лікарів-ендокринологів. Захід зібрав провідних фахівців у сфері остеопорозу, порушень кісткового метаболізму, обміну вітаміну D, які ділилися своїми знаннями і досвідом з присутніми більше, ніж 70 лікарями.
17.10.2017
Завдяки сучасним методам лікування ВІЛ на сьогоднішній день не є вироком. Це захворювання успішно піддається лікуванню, головне вчасно пройти необхідну діагностику і дізнатися свій ВІЛ-статус.
12.10.2017
В епідемічному сезоні захворюваності на грип та гострі респіраторні інфекції 2017/2018 фахівці прогнозують циркуляцію 3 штамів грипу, один з яких є новим для України і тому викликає побоювання через слабкий до нього імунітету у населення.
05.10.2017
В суботу 30.09.2017 р. в жіночій консультації КДЦ Печерського району за адресою: м. Київ, бул. Лесі Українки, 36В відбувся практикум для жінок елегантного віку 45+ «Золота осінь жінки», в якому взяла участь медична лабораторія ДІЛА в якості експерта з лабораторних досліджень.
05.10.2017
01.10.17 р. МЛ ДІЛА в рамках діагностичного напряму «Оцінка стану кальцій-фосфорного обміну» впровадила інновацію ß-CROSS LAPS (С-термінальний телопептид колагену I типу) - маркер руйнування кісткової тканини.
02.10.2017
Вітаємо усіх працівників найгуманнішої та найшанованішої професії з Міжнародним днем лікаря та дякуємо кожному з вас за сумлінну та невтомну працю.
26.09.2017
Ласкаво просимо вас до нового відділення лабораторії ДІЛА у Києві, що знаходиться у центрі Києва поруч з м. Лук'янівська за адресою вул. Січових Стрільців, 103.
26.09.2017
Дисменорея - патологічний стан, що характеризується порушенням менструального циклу та виникненням больового синдрому під час менструації.
22.09.2017
МЛ ДІЛА піклується про здоров’я кожного з вас і пропонує скористатись чудовою нагодою пройти лабораторне обстеження зі знижкою 10%. Акція діє у відділенні, що розташоване за адресою вул. Булаховського, 26 в районі м. Академмістечко.
12.09.2017
Хронічні лімфопроліферативні хвороби (ХЛПЗ) об'єднують групу біологічно різних пухлин. Найрозповсюдженіша форма лімфопроліферативних захворюваннь у світі за даними ВООЗ - хронічний лімфоцитарний лейкоз.
12.09.2017
МЛ ДІЛА пропонує нове дослідження «Eозінофільний катіонний білок» (ECP) - неінвазивний маркер еозинофільного запалення при алергічних захворюваннях і інших станах, пов'язаних з активацією еозинофілів.
15.08.2017
Біохімічне дослідження крові - універсальний метод лабораторної діагностики, що дозволяє оцінити роботу внутрішніх органів і систем організму, розпізнати порушення метаболізму
04.08.2017
Біль у суглобах - один з найпоширеніших типів хронічного болю і одна з провідних причин непрацездатності. Від болю у спині та суглобах щорічно страждає близько 90% дорослого населення і за кількістю випадків звернення за медичною допомогою суглобовий біль поступається лише простудним захворюванням.
13.07.2017
Загальновідомо, що вітамін D, перш за все, відіграє ключову роль в кальцієво-фосфорному обміні і впливає на мінеральну щільність кісткової тканини. Ці «класичні» функції дозволили застосовувати препарати вітаміну D для профілактики рахіту у дітей, а також для профілактики та лікування остеопорозу у дорослих.
07.06.2017
Термін «хронічна хвороба нирок» об'єднує безліч різних захворювань сечовивідної системи, пов'язаних з різким погіршенням якості життя, високою смертністю і призводять в термінальній стадії до необхідності застосування дорогих методів замісної терапії - діалізу та пересадки нирки.